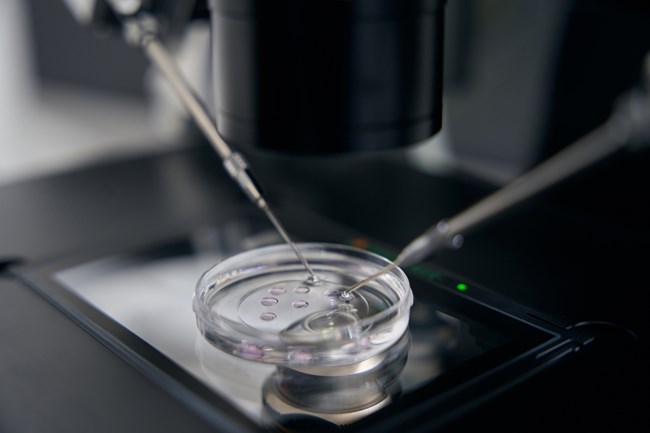

Ένα υγιέστατο κοριτσάκι γεννήθηκε πρόσφατα από μια 44χρονη ασθενή σε ελληνική μαιευτική κλινική, μέσω γονιμοποίησης δικών της ωαρίων που καταψύχθηκαν το 2013. Η διαδικασία απόψυξης και γονιμοποίησης των ωαρίων πραγματοποιήθηκε με επιτυχία το 2023, δέκα χρόνια αργότερα, με θεράποντα ιατρό τον Δρ. Ιωάννη Ζερβομανωλάκη, Μαιευτήρα - Γυναικολόγο, Ειδικό στην Υποβοηθούμενη Αναπαραγωγή.
Μια εξαιρετική ομάδα καταξιωμένων γιατρών και ειδικών με εξειδίκευση στην υποβοηθούμενη αναπαραγωγή και εμβρυολόγους που έχουν λάβει εκπαίδευση σε κορυφαία κέντρα παγκοσμίως, με τη μεγαλύτερη εμπειρία στον τομέα της υποβοηθούμενης αναπαραγωγής στη χώρα μας, δίνουν " ελπίδα" σε όλες τις γυναίκες, ειδικά όσες επιθυμούν να αποκτήσουν παιδί σε μεγαλύτερη ηλικία.
Όπως αναφέρει ο Δρ. Ιωάννης Zερβομανωλάκης για την σπάνια περίπτωση: "Πρόκειται για ένα από τα μεγαλύτερα σε διάρκεια διαστήματα κατάψυξης ωαρίων που οδήγησε σε γέννηση παιδιού, τόσο στην Ελλάδα, όσο και διεθνώς, με βάση τις δημοσιευμένες περιπτώσεις. Αποδεικνύεται με τον καλύτερο τρόπο ότι η κατάψυξη ωαρίων σε Μονάδες με την αντίστοιχη εμπειρία είναι ασφαλής, τόσο για γυναίκες με ιατρικό ιστορικό, όσο και για γυναίκες που καταψύχουν τα ωάριά τους σε νεαρή ηλικία για να ολοκληρώσουν αργότερα τον οικογενειακό τους προγραμματισμό".
Ο θεράποντας ιατρός πρόσθεσε, επίσης, ότι στόχος είναι "όλο και περισσότερες Ελληνίδες να καταψύχουν τα ωάριά τους έγκαιρα, ειδικά μετά την τελευταία αλλαγή του νόμου, που επιτρέπει τη φύλαξη κατεψυγμένων ωαρίων και πέραν της δεκαετίας".
Η κατάψυξη ωαρίων παρέχει τη δυνατότητα στη γυναίκα να διατηρήσει τα επίπεδα γονιμότητάς της για όσο χρονικό διάστημα επιθυμεί, ενώ παράλληλα αποτελεί την πιο ασφαλή και αξιόπιστη μέθοδο.
Τα ωάρια, τα οποία καταψύχονται, διατηρούνται αναλλοίωτα και χρησιμοποιούνται σε μεταγενέστερο χρονικό σημείο, προκειμένου να επιτευχθεί εγκυμοσύνη με τη μέθοδο της εξωσωματικής γονιμοποίησης.
Πρόκειται για μία τεχνική, η οποία αναπτύσσεται τα τελευταία 20 περίπου έτη ως μια καινούργια μέθοδος υποβοηθούμενης αναπαραγωγής.
Ακολουθήστε το Womantoc στο Instagram